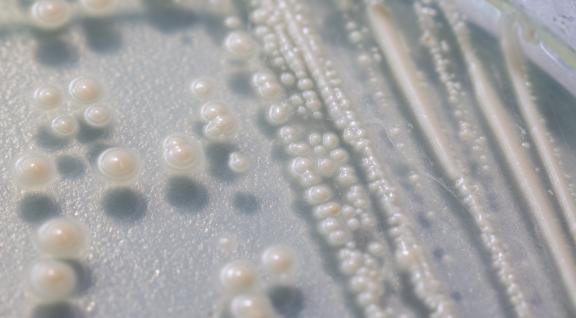

Safe-by-Design coaching voor studenten
Dit jaar vond alweer de 16e editie van iGEM plaats, de grootste synthetische biologie competitie voor studententeams.

Dit jaar vond alweer de 16e editie van iGEM plaats, de grootste synthetische biologie competitie voor studententeams.

Wat betekent Safe-by-Design voor de biotechnologie? Doen we de dingen goed? En welke veiligheidsvragen komen bij nieuwe biologische ontwikkelingen naar voren?

Onderzoekers hebben aangetoond dat een vaccin, geproduceerd door planten, zeebaars bescherming biedt tegen een virusziekte.

Onderzoekers hebben een elektronische sensor ontwikkeld die gebruik maakt van CRISPR-technologie.

Onderzoekers hebben een nieuwe test methode ontwikkeld waarmee verschillend geprogrammeerde bacteriën tegelijkertijd getest kunnen worden op hun antitumorwerking.
De Amerikaanse organisatie ‘Engineering Biology Research Consortium’ (EBRC) heeft deze zomer een routekaart uitgebracht die richting geeft aan de verdere ontwikkeling van de bioeconomi

Onderzoekers toonden recent aan dat de malaria mug bestreden kan worden met een schimmel die een spinnen-gif produceert.

Bacteriofagen zijn virussen die het specifiek gemunt hebben op bepaalde bacteriën.

Sinds enige tijd vinden steeds meer burgerwetenschapsprojecten plaats met de intentie om het publiek te betrekken bij wetenschappelijk onderzoek of om meer gegevens te kunnen verz

Eind vorig jaar ging schokkend nieuws de wereld over: in China was een tweeling geboren waarvan het embryonale DNA genetisch gemodificeerd was met CRISPR technologie.
